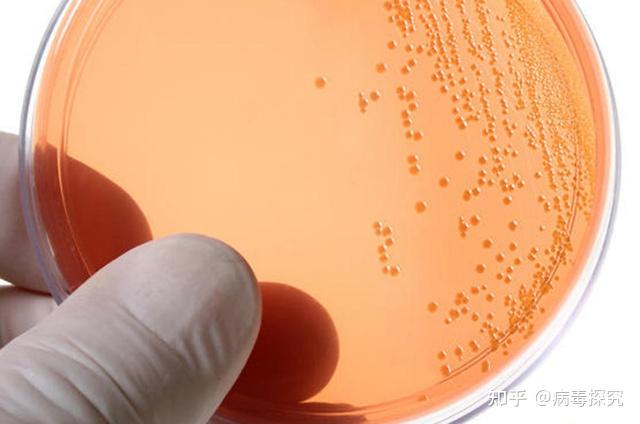
硝化细菌硫化细菌铁细菌氢细菌对农业生产和环境有什么影响

氢细菌

从3大方面看氢分子医学应用的安全性!
图片尺寸1200x800
南极细菌靠空气生存,并以氢为燃料制造水
图片尺寸750x413
氢细菌(地理)
图片尺寸309x220
natcommun细菌利用过氧化氢削弱免疫系统引发肺炎
图片尺寸640x453
过氧化氢灭菌器是制药厂无菌室消毒灭菌技术的新选择
图片尺寸1000x729
后生元?氢气是一种双生元!
图片尺寸1200x900
1.典型的细菌一般带负电荷.过氧化氢干雾微粒被吸引到其周围.2.
图片尺寸610x272
过氧化氢银复合型消毒剂在学校社区直饮水管道冲洗消毒应用探讨
图片尺寸900x664
避免了耐药性的产生,同时为皮下细菌感染的治疗提供了一种新的思路
图片尺寸1080x1170
缓解过敏益生菌可以产生有机酸,游离脂肪酸,过氧化氢细菌素,抑制有害
图片尺寸516x344
硝化细菌硫化细菌铁细菌氢细菌对农业生产和环境有什么影响
图片尺寸640x424
温度影响污泥厌氧消化制氢_生活常识_中睿百科网
图片尺寸640x425
包学习
图片尺寸640x426
兼性厌氧,无芽孢的细胞内杆状细菌,在血琼脂上生长时为过氧化氢酶阳性
图片尺寸1000x750
益生菌可产生有机酸,游离脂肪酸,过氧化氢细菌素,抑制其它的有害菌的
图片尺寸704x396
三种化学诱变剂对产氢细菌ethanoligenenssp_zgx4的诱变效应
图片尺寸907x1245
这幅梵高的星空复刻图竟是用细菌画的连细菌都来搞艺术了
图片尺寸583x549
微生物代谢ppt
图片尺寸1080x810
大程度地吸收可见光——这一形貌和结构特征与自然界光合细菌具有一定
图片尺寸717x628
化能自养类型: 硝化细菌,铁细菌,硫细菌,氢细菌等 nh3 o2 → hno2
图片尺寸1080x810